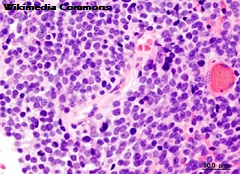
cancer

Notícias
- Detalhes
 23º SIICUSP 2015
23º SIICUSP 2015
Parabéns aos envolvidos no 23º SIICUSP!
A Diretoria do IB agradece a participação de todos os que fizeram e visitaram o 23º Simpósio Internacional de Iniciação Científica da USP. Os melhores trabalhos serão selecionados para a segunda etapa do Simpósio, a ocorrer em outubro, quando pesquisas de todas as unidades estarão reunidas em um evento central e organizado diretamente pela Pró-Reitoria de Pesquisa.
- Detalhes
 Transição catastrófica do Cantareira
Transição catastrófica do Cantareira
Cientistas afirmam que Cantareira sofreu uma transição catastrófica
A revista científica PLoS ONE publicou um artigo sobre a crise hídrica em São Paulo escrito por pesquisadores da USP (Profº Dr. Paulo Inácio Prado, do Departamento de Ecologia do IB/USP) e da UNESP (Renato Mendes Coutinho e Roberto Kraenkel). É a primeira publicação científica internacional sobre o assunto que usa dados sobre o sistema Cantareira, métodos estatísticos e modelagem matemática para avaliar o que ocorreu. Os autores concluem que o sistema Cantareira sofreu uma transição catastrófica, passando rapidamente de condições normais para um estado de ineficiência. Essa transição ocorreu em janeiro de 2014. Ações que poderiam ter detido a transição deveriam ter sido tomadas antes desta data.
O motor da transição é o que é chamado popularmente de “efeito esponja”. Em situação de normalidade, há muita água no reservatório e na bacia hidrográfica. Boa parte da água da chuva vai para os reservatórios, mantendo o sistema no estado normal. Temos um círculo virtuoso. Já numa situação de seca, o volume do sistema é mais baixo e o solo absorve mais da água que iria para o reservatório, o que faz o seu nível baixar mais ainda. Neste caso, há um círculo vicioso. A passagem do círculo virtuoso ao vicioso é uma transição que acontece em poucos meses. Para evitá-la é preciso monitorar o sistema e retirar menos água quando houver o risco de transição.
Perda de resiliência
Transições críticas não são novidade para cientistas, que as associam ao conceito de resiliência. Intuitivamente, resiliência é a capacidade de um sistema de voltar ao mesmo estado depois de ter sido perturbado. Com a perda da resiliência de um estado, acontece uma transição - um salto para um outro estado. Uma analogia pode ser traçada com o caso de um barco num lago. Normalmente o vento e as ondas não fazem o barco virar. Ele está numa posição resiliente. Todos sabemos, porém, que em condições excepcionais um barco pode virar - e isso acontece de uma forma rápida. O problema é que a posição do barco virado também é resiliente e é necessário um grande esforço para desvirá-lo.
Alguns casos de perda de resiliência na natureza são bem estudados. Um caso bem conhecido é o do processo de desertificação. O trabalho publicado pelos cientistas brasileiros mostra que esta perda de resiliência também pode ocorrer em reservatórios de água, como aconteceu no Cantareira: a perda do estado normal de operações levou-o a um regime de ineficiência. E o custo para sair dele é alto: é necessário retirar o mínimo possível de água, com as consequências que todos conhecemos.
Olhando para o futuro
Os resultados obtidos pelo grupo mostram que o gerenciamento de um reservatório deve levar em conta a possibilidade de transições catastróficas. O padrão anteriormente utilizado – baseado na chamada “curva de aversão ao risco” – indicava uma situação de normalidade até dezembro de 2013, o que o trabalho publicado na PLoS ONE mostra que não era real. Isto quer dizer que é necessário definir novos parâmetros de operação a partir de conhecimentos científicos atuais. Os métodos desenvolvidos no trabalho são os mesmos usados para fazer projeções sobre a evolução do sistema Cantareira desde abril no site Águas Futuras.
Confira o artigo na íntegra: Coutinho RM, Kraenkel RA, Prado PI (2015) Catastrophic Regime Shift in Water Reservoirs and São Paulo Water Supply Crisis. PLoS ONE 10(9): e0138278. doi: 10.1371/journal.pone.0138278
Fonte:Águas Futuras
- Detalhes
Avanços no estudo do câncer
Avanços no estudo do câncer
O grupo do professor Dr. Keith Okamoto, do Departamento de Genética e Biologia Evolutiva do IB/USP, tem investigado genes que conferem às células tumorais malignas características de células-tronco. Em entrevista à Revista FAPESP, o pesquisador explica a relação. "Esses genes, quando expressos, não são simplesmente marcadores de um pior diagnóstico. Eles contribuem ativamente para a agressividade tumoral. São, portanto, alvos terapêuticos a serem explorados", afirmou. Os genes em questão codificam fatores relacionados à pluripotência - capacidade de gerar células dos três tecidos embrionários - e deveriam estar sendo expressos em células-tronco embrionárias. Análises de células de meduloblastoma - o principal câncer cerebral em crianças -, no entanto, mostraram que estes mesmos genes ofereceriam a elas propriedades de células-tronco, como alta capacidade de autorrenovação e disseminação pelo corpo.
- Detalhes
 Convênio Acadêmico Internacional
Convênio Acadêmico Internacional
Acaba de ser aprovado o convênio acadêmico internacional entre o IB/USP e a Faculdade de Ciências Sociais da University of Victoria (Canadá).
O convênio visa a coorientação de alunos de mestrado e doutorado e a dupla-titulação.
Já temos a adesão da doutoranda Rebeca Veronica Ribeiro Viana, do Depto de Botânica, sob orientação do Prof. Dr. Paulo Takeo Sano.
Caso haja interesse na adesão ou em obter maiores informações sobre os procedimentos para firmar convênios do mesmo tipo, entrar em contato através do endereço cpg@ib.usp.br
- Detalhes
 A profª Lygia da Veiga, do Departamento de Genética e Biologia Evolutiva do IB/USP, participou do último Simpósio Internacional de Pesquisas com Células-Tronco, realizado na Suécia, na última semana de julho. O evento teve a participação de 3500 profissionais da área de 66 países, que juntos discutiram sobre os atuais limites da ciência no que cerne a terapia com células-tronco (CTs). A professora ressalta que "apesar dos avanços, essas terapias ainda estão restritas ao âmbito das pesquisas, e nenhum médico pode receitá-las a seus pacientes. Até hoje, o único tratamento consolidado com CTs é o transplante de medula óssea ou de sangue de cordão umbilical para o tratamento de, principalmente, doenças hematológicas".
A profª Lygia da Veiga, do Departamento de Genética e Biologia Evolutiva do IB/USP, participou do último Simpósio Internacional de Pesquisas com Células-Tronco, realizado na Suécia, na última semana de julho. O evento teve a participação de 3500 profissionais da área de 66 países, que juntos discutiram sobre os atuais limites da ciência no que cerne a terapia com células-tronco (CTs). A professora ressalta que "apesar dos avanços, essas terapias ainda estão restritas ao âmbito das pesquisas, e nenhum médico pode receitá-las a seus pacientes. Até hoje, o único tratamento consolidado com CTs é o transplante de medula óssea ou de sangue de cordão umbilical para o tratamento de, principalmente, doenças hematológicas".
Confira a coluna completa na Revista Ser Médico, do Conselho Regional de Medicina do Estado de São Paulo.

